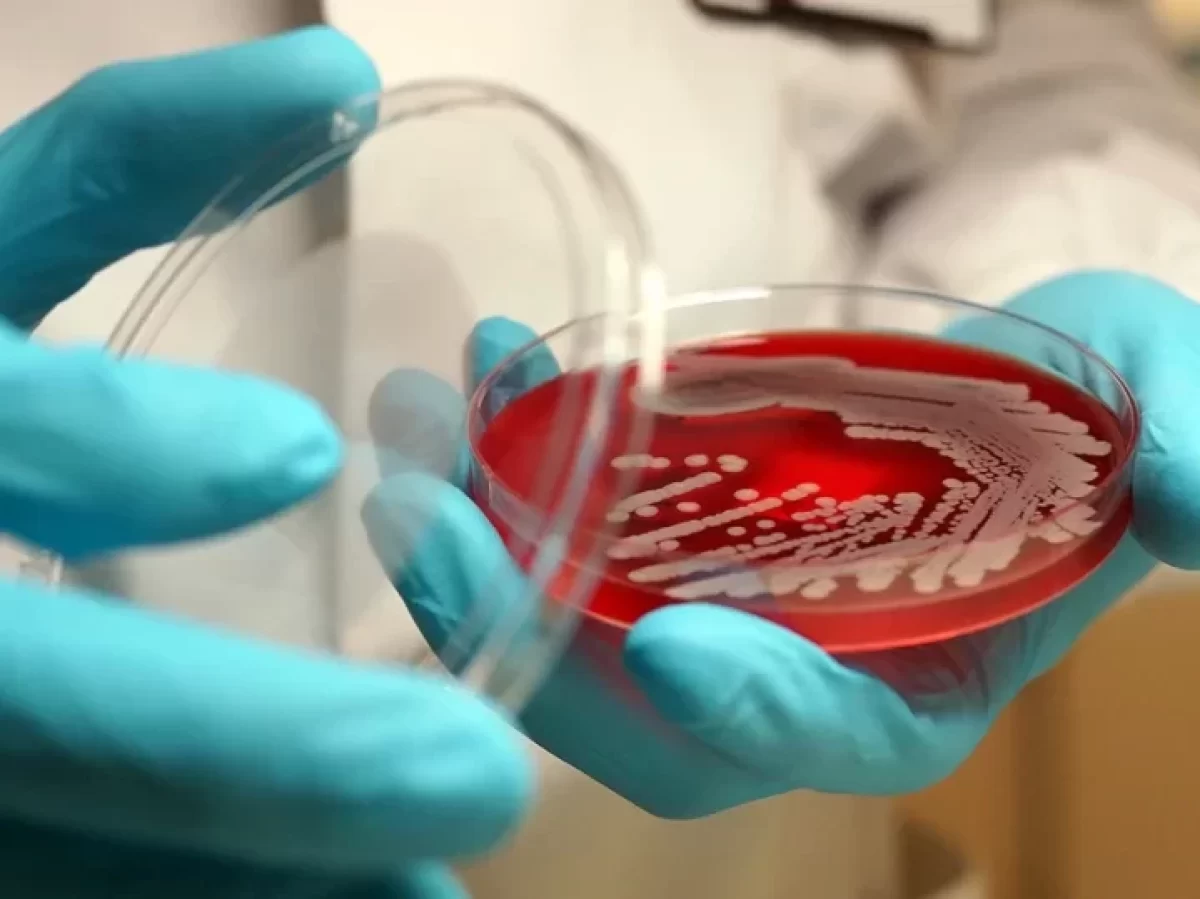

V Antarktidě byly objeveny bakterie se superschopnostmi. To je závažný problém pro nás všechny
Jako bychom neměli dost problémů s rezistencí vůči antibiotikům a globálním oteplováním, objevil se další. V Antarktidě byly objeveny bakterie s přirozenou odolností vůči antibiotikům a antimikrobiálním látkám. Odborníci varují, že by se tyto patogeny mohly brzy rozšířit i mimo polární oblasti, jak píše server Science Direct.
Antibiotická rezistence označuje schopnost bakterií odolávat účinkům antibiotik. Patogeny to dělají mnoha způsoby, ale výsledek je vždy stejný. Schopnost volně se množit v přítomnosti antibiotika a předávat tuto schopnost dalším generacím.
Rezistence vůči antibiotikům je závažný problém. Světová zdravotnická organizace (WHO) ji dokonce označuje za jednu z největších výzev lidstva. Za nárůst rezistence vůči antibiotikům si bohužel můžeme sami a přispívá k tomu iracionální předepisování antibiotik a jejich užívání v rozporu s lékařským doporučením. U virových infekcí se stále běžně předepisují antibiotika.

Tým vědců z chilské univerzity nyní zjistil, že bakterie žijící v Antarktidě mají geny, které jim dávají přirozenou odolnost vůči antibiotikům. To je vážný problém, protože pokračující globální oteplování by mohlo způsobit, že tyto patogeny uniknou z polárních oblastí.
„Víme, že v půdě Antarktického poloostrova, jedné z polárních oblastí nejvíce postižených táním ledu, se vyskytují bakterie s obrovskou rozmanitostí. A že některé z nich jsou potenciálním zdrojem genů předků, které propůjčují odolnost vůči antibiotikům. Je třeba si položit otázku, zda změna klimatu může mít vliv na výskyt infekčních onemocnění. Podle možného scénáře by tyto geny mohly opustit svůj rezervoár a podpořit vznik a šíření infekčních chorob,“ řekl vědec.
Andres Marcoleta, který vedl studii publikovanou v časopise Science of the Total Environment, uvedl, že tyto „superschopnosti“, které se vyvinuly, aby odolávaly extrémním podmínkám, jsou obsaženy v mobilních fragmentech DNA, které lze snadno přenést na jiné bakterie.
Zdroj: sciencedirect.com
Nejnovější články
- Jeden nespokojený senior může zablokovat stavbu celého satelitního městečka o několika domech
- Kalifornie testuje autobusy s rychlostí 225 km/h. Pro svou zběsilou jízdu budou mít vlastní pruh na dálnici
- Některé České restaurace trestají nedojedená jídla poplatkem. Kdo nedojí, připlatí si
- Cyklistický airbag může být rozhodujícím prvkem pro záchranu života. Objevují se hlasy pro jeho povinné zavedení
- Ukrajina tak dlouho žádala USA o zbraně dlouhého doletu, až se je naučila vyrábět sama
- Psychologie říká, že lidé, kteří dosáhnou 70 let a uvědomí si, že je jejich děti již nepotřebují, mohou pociťovat hluboký dopad na své duševní zdraví
- Zpráva evropských úřadů potvrzuje: hrozny, jahody a pomeranče jsou ovoce nejvíce kontaminovány pesticidy
- Kbelík a mop mají své dny sečteny: odborníci na úklid sdílejí stejný názor a v roce 2026 se přiklánějí k jeho vylepšené verzi
- Blíží se úplné zatmění slunce: Dočkáme se ho v létě a bude to nádherná podívaná
- Je konec: Legendární švédská automobilka po 75 letech končí prodejem posledních vyrobených aut